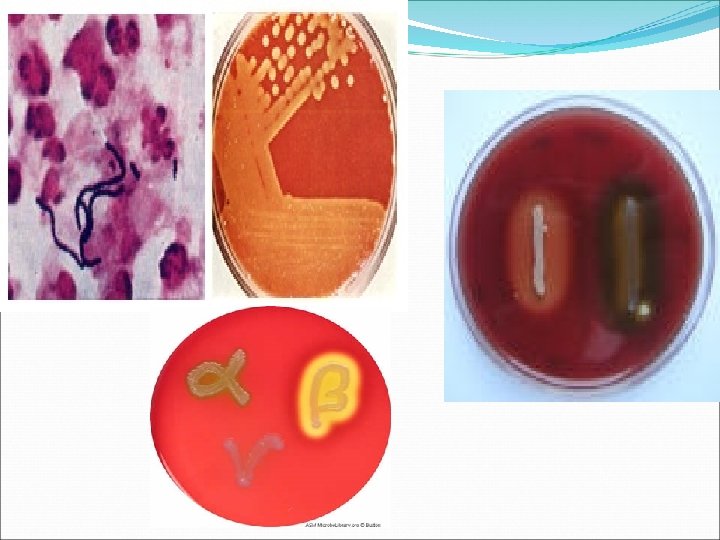

Genul Staphylococcus Caractere Generale Apartine familiei Micrococcaceae Coci




























































- Slides: 60

Genul Staphylococcus

Caractere Generale Apartine familiei Micrococcaceae Coci Gram pozitivi Imobili Nesporulati In vivo majoritatea produc capsula Aerobi- anaerobi facultativi Cresc în prezenţa clorurii de sodiu 7, 5% (halotoleranţi) Catalazo – pozitivi

Reprezentati S. aureus - întâlnit la purtătorii sănătoşi în cavitatea nazală, în faringe, pe tegumente, în intestin responsabil de majoritatea infecţiilor umane stafilococice S. epidermidis microbiocenoza nazală şi cutanată => infecţii oportuniste la pacienţii imunosuprimaţi: cistite, septicemii, endocardite, meningite S. saprophyticus –infectii urinare

�Stafilococi coagulazo pozitivi: S. aureus cu rol major în patogenitate � Stafilococi coagulazo negativi: prezenţi în microbiocenoze cu anumite localizări preferenţiale - S. capitis , S. epidermidis


Infectii produse Infectii cutanate supuraţie intensă, elemente de necroză locală şi prin formarea unor abcese locale 1. Piodermita (impetigo) - infecţie superficială a pielii, foarte contagioasă: vezicule care conţin un fluid incolor sau colorat în galben, cel mai adesea situate la extremităţi, urmând traumelor pielii. 2. Foliculite: infecţii ale foliculului pilos 3. 4. 5. 6. 7. Furuncule: extinderea infecţiei în ţesutul celular subcutanat Hidrosadenita Abcese Carbuncul: focare multiple şi extinse în profunzime Panaritiu





Infectii produse Infectii respiratorii: bronsite, pneumonii, sinuzite, otite, pleurezii, abcese pulmonare Infectii urinare: cistite, cistopielite, pielonefrite, abces renal Infectii genitale: endometrite, anexite, septicemii postabortum Meningite, abcese cerebrale Endocardite, pericardite Infecţii digestive: toxiinfectii alimentare, enterocolite post antibiotice

�Artrite �Osteomielite �“sindrom de piele oparita” �Sindrom de soc toxico-septic �Septicemii

Diagnostic 1. Recoltarea produselor patologice: puroi LCR urina sange alimente materii fecale aspiratii bronsice

Diagnostic 2. Examen microscopic direct Coci Gram pozitivi asezati in gramezi nesporulati

3. Izolarea

Diagnostic 4. Identificarea se face pe baza: �Proprietatilor morfotinctoriale �Proprietatilor de cultura �Caracterelor de patogenitate

Factori de patogenitate 1. De suprafata Peptidoglicanul are acţiune: - dermonecrotică: determină leziuni tegumentare - citotoxică pentru fibra cardiaca - proinflamatorie prin stimularea producerii de citokine (CTK): IL-1, TNF α şi prin activarea C’ - agreganta plachetară Capsula -confera rezistenţa la antibiotice - permite aderare de suprafeţe inerte -rol antifagocitar

1. Factori de patogenitate de suprafata proteina A - aderarea de epitelii - inhiba fagocitoza - fixeaza porţiunea Fc a moleculelor Ig G, prevenind anticorpii specifici să adere de bacterie şi previne opsonizarea - declanşeaza o reacţie inflamatorie intensa prin activarea sistemului Complement de către complexul proteină A – imunglobuline. - determina agregare plachetara şi CID împreună cu peptidoglicanul acizii teichoici- atasarea de epitelii coagulaza legata- atasarea de fibrinogen

2. Enzime Coagulaza- marker al patogenitatii Este de 2 tipuri: liberă cauzează coagularea plasmei legată formeaza un manşon de fibrină în jurul stafilococilor, prevenind fagocitoza. Lipaze Nucleaze - DRN-aza: clivează acizii nucleici celulari; -RN-aza

2. Enzime Hialurondaza- hidrolizeazặ acidul hialuronic din ţesutul conjunctiv, cu rol în răspândirea bacteriilor Fibrinolizina -activează plasmingenul în plasmină, care lizeazặ fibrina Fosfataze Catalaze Superoxidbismutaze Proteaze: degradeaza colagenul Elastaze

3. Toxine Citolitice- lizeaza suprafata celulelor: hematii, leucocite, hepatocite Hemolizine - Hemolizina α- efect hemolitic, leucocidal, dermonecrotic, letal -lizeazã hematii de iepure, oaie -produce dermonecroză şi are efect letal la iepure -Hemolizina (sfingomielinaza)- acţionează asupra sfingomielinei din membrana hematiilor Determină hemoliza de tip“ cald-rece” şi perturba fagocitoza. - Hemolizina - efect citotoxic asupra limfoblastelor - funcţie leucotoxica pe macrofage, PMN şi funcţie hemolitică - Hemolizina -determina liza hematiilor acţiune detergent-like: solubilizeaza fosfolipidele membranare efect citotoxic pentru PMN macrofage, limfocite

3. Toxine leucocidine � sunt prezente la majoritatea stafilococilor patogeni � acţiune leucotoxica şi dermonecrotica � intervin în producea leziunilor cutanate necrotizante şi a pneumoniilor necrotizante � omoară PMN şi macrofagele � rol important în invazivitate (perturba fagocitoza) � stimuleaza producerea de mediatori ai inflamaţiei (IL 8)

Toxine cu patologie specifica �Enterotoxine 7 tipuri antigenice de enterotoxine notate cu A, B, C 1 -3, C, D şi E. � sunt produse şi eliberate de S. aureus grup fagic III � proteine stabile: rezistente la enzimele digestive şi la temperatură (sunt termostabile): rezistă 30 min. la 100 0 C (la fierbere) � responsabile pentru majoritatea toxiinfecţiilor alimentare mai frecvent enterotoxina de tip A, mai rar enterotoxina D, C, B � enterocolite acute pseudomembranoase, post antibioticoterapie � Intervine mai ales enterotoxina de tip A şi mai rar enterotoxina D, C, B

Toxine cu patologie specifica Exfoliatina -boli cutanate cu exfoliere dermicặ, observate mai ales la copii “sindrom de piele opărită” - (SSSS: staphylococcal scalded skin syndrome) - infecţiile cutanate încep cu eritem şi sfârşesc cu exfoliere cutanată -produce epidemoliza cu dezlipirea stratului granulos din cel spinos, ceea ce conduce la desprindere de lambouri cutanate

Toxine cu patologie specifica �TSST-1 (toxina sindromul de şocul toxic) are determinism cromozomial este aproape identică cu enterotoxina F cauzează febră, multiple disfuncţii organice şi şoc. Perturbă forţele de adeziune între celulele granulare din derm, cauzând exfoliere cutanată.

Genul Streptococcus

Caractere generale �Coci Gram pozitivi dispusi in lanturi de dimensiuni variabile �Imobili �nesporulati

GENUL STREPTOCOCCUS Frotiu din cultura de streptococ Frotiu din produs patologic

GENUL STREPTOCOCCUS S. PNEUMONIAE STRUCTURA S. PNEUMONIAE- FROTIU DIN PRODUS PATOLOGIC

Clasificare �Dupa aspectul hemolizei: � Hemoliza α- hematiile nu sunt decat partial lizate, coloniile fiind incojurate de un halou verzui: S. viridans � Hemoliza β- hematiile sunt complet lizate, coloniile sunt inconjurate de o zona de hemoliza totala: S. pyogenes � Hemoliza γ- absenta hemolizei: S. faecium

Clasificare Pe baza proprietatilor antigenice ale peretelui (Lancefield): pe baza polizaharidului C: �Grup A- β hemolitici � Majoritatea infectiilor umane �Grup B- infectii neo-natale, otite, traheobronsite, infectii urinare, genitale, meningite �Grup D- prezent la nivelul T, implicat in afectiuni ale ap uro-genital �Grup C si D- afectiuni cutanate, ap respirator superior, tract genital

CLASIFICAREA STREPTOCOCILOR

S. pyogenes = s. β hemolitic de grup A �Angina eritematoasa �Scarlatina �Erizipel �Pneumonii, otite, sinuzite, artrite, septicemii �Complicatii poststreptococice: GNA RAA

INFECTII PRODUSE ANGINA SCARLATINA

INFECTII PRODUSE ERIZIPEL

Caria dentara �S. mutans �S. salivarius → placa dentara: liza smalt + alte tesuturi dentare=>CARIA !!!pot trece din cavitatea bucala in sange

Pneumococul (S. pneumoniae) �Coci G + �in diplo �Varf de lance �Capsulati �> 80 tipuri ÞPneumonia franca lobara ÞMeningite (copii) ÞOtite Þendocardite

Diagnostic 1. 2. 3. 4. R. p. p: secretie faringiana /puroi /urina /LCR Examen microscopic direct: coci G + in lanturi Izolarea: geloza sange: colonii mici, punctiforme, inconjurate sau nu de hemoliza Identificarea: pe baza proprietatilor: morfotinctoriale de cultura biochimice de patogenitate: s. β hemolitic de grup A- exotoxine: streptolizina O si S, hialuronidaza, nucleaza, proteinaza

�Antibiograma! �Diagnostic serologic: ASLO=> evidentiaza in serul bolnavilor Atc antistreptolizina O

Diagnostic- pneumococ 1. R. p. p: sputa /lichid pleural /secretii otice /LCR 2. Examen microscopic direct: coci G + in diplo, capsulati 3. Izolarea: geloza sange: colonii S inconjurate de hemoliza α asemanatoare S. viridans geloza socolatie

Diagnostic- pneumococ 4. Identificarea: pe baza proprietatilor: morfotinctoriale de cultura biochimice: sensibili la optochin antigenice: => tip (r. de umflare a capsulei) de patogenitate: soarecele este animalul cel mai sensibil

Diagnostic- pneumococ �Antibiograma –obligatorie !!!

Genul Neisseria

Neisserii �Cei mai importanti coci G care intervin in patologia umana �Specii comensale (pe mucoase) �Specii patogene: N. gonorrhoeae si N. meningitidis

N. gonorrhoeae �Parazit strict al omului=> gonorea=blenoragia= MTS CLINIC �barbati: uretrita acuta: secretie uretrala purulenta, abundenta disurie netratata: stricturi uretrale, prostatite, epididimite

N. gonorrhoeae �femei: inaparenta clinic infectie manifesta: uretrite, salpingite, cervicite →STERILITATE Diseminare hematogena: artrite, endocardite, meningite �Nou-nascuti- conjunctivita gonococica a nou-nascutului - instilare in sacul conjunctival de azotat de Ag 1%

Diagnostic bacteriologic 1. Recoltarea p. p: secreetie uretrala secretie endocervicala conjunctivala

Diagnostic bacteriologic 1. Examenul microscopic direct: Gram/ albastru de metilen numeroase PMN si diplococi reniformi localizati intracelular dar mai ales extracelular

GENUL NEISSERIA -schema NEISSERIA frotiu din produs patologic


Diagnostic bacteriologic 2. Izolarea: medii complexe: geloza chocolatie medii cu substante nutritive la care se adauga AB ! insamantare imediat dupa recoltare colonii S, gri, transparente

Diagnostic bacteriologic 3. Identificarea se face pe baza proprietatilor: � � � morfotinctoriale de cultura biochimice: testul oxidazei + fermenteaza glucoza 4. Antibiograma Profilaxie: informarea pacientilor despre riscurile bolii netratate si necesitatea tratarii partenerilor

N. meningitidis �Bacterie strict umana �Poate fi izolata si din nasofaringele purtatorilor sanatosi Þmeningita cerebrospinala epidemica !! Meningita cerebrospinala este o urgenta medicala !! Izolarea pacientului

Meningita cerebrospinala epidemica Porta de intrare: mucoasa repiratorie Clinic: 1. rinofaringita initiala 2. scurta perioada de septicemie 3. localizarea meningeala a b: cefalee, varsaturi, febra, fotofobie, artralgii tratament antibiotic insuficient: semne mascate !! Fara tratament boala e mortala

INFECTII PRODUSE MENINGITA MENINGOCOCICA

Diagnostic de laborator �Recoltarea pp: LCR ! inainte de inceperea tratamentului AB secretie nazala (epidemii de meningita)

Diagnostic de laborator Examenul microscopic direct Frotiu Gram: coci G – reniformi asezati in perechi intra si extracelulari albastru de metilen Ziehl-Neelsen Izolarea: geloza chocolatie => colonii S, “picaturi de roua” , usor gri, transparente

CARACTERE DE CULTURA NEISSERIA- GELOZA SANGE NEISSERIA-GELOZA SOCOLATIE

Diagnostic de laborator �Identificarea se face pe baza caracterelor: morfotinctoriale de cultura biochimice: testul oxidazei + fermenteaza glucoza si lactoza antigenice: antigene de capsula-poli. Z → 8 serogrupe: A, B, C, 29 E, X, Y Z, W 135 de patogenitate: virulenta e legata de structura Atg ! OMUL- singura gazda naturala